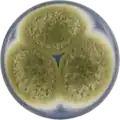

Aspergillus pseudocaelatus
| Aspergillus pseudocaelatus | |
|---|---|
| Scientific classification | |
| Kingdom: | Fungi |
| Division: | Ascomycota |
| Class: | Eurotiomycetes |
| Order: | Eurotiales |
| Family: | Aspergillaceae |
| Genus: | Aspergillus |
| Species: | A. pseudocaelatus
|
| Binomial name | |
| Aspergillus pseudocaelatus Varga, Frisvad & Samson, 2011[1]
| |
Aspergillus pseudocaelatus is a species of fungus in the genus Aspergillus. It was first isolated from an Arachis burkartii leaf in Argentina. It is most related to the non-aflatoxin producing Aspergillus caelatus, producing aflatoxins B and G, as well as cyclopiazonic acid and kojic acid.[1]
Growth and morphology
A. pseudocaelatus has been cultivated on both Czapek yeast extract agar (CYA) plates and Malt Extract Agar Oxoid® (MEAOX) plates. The growth morphology of the colonies can be seen in the pictures below.
-
Aspergillus pseudocaelatus growing on CYA plate
Aspergillus pseudocaelatus growing on CYA plate -
 Aspergillus pseudocaelatus growing on MEAOX plate
Aspergillus pseudocaelatus growing on MEAOX plate
References
Further reading
- Lakkireddy K, Kasturi K, KRS SR (2014). "Aflatoxins in Food and Feed: The Science of Safe Food" (PDF). Practice. 3: 5.
- Andersson, Ellinor (2012). "A small growth study of Aspergillus section Flavi, and potentially aflatoxigenic fungi and aflatoxin occurrence in Brazil nuts from local markets in Manaus, Brazil" (PDF). Uppsala: SLU, Dept. of Microbiology. urn:nbn:se:slu:epsilon-s-1782.